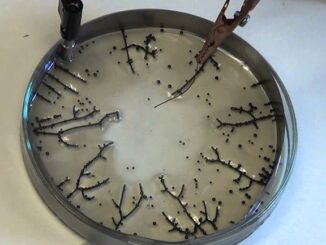
Graphene-like substance being shed from vaccinated to unvaccinated, doctor warns

A ‘Bird Flu’ Narrative Is Being Established By The Ruling Class
The ruling class, with the help of the mainstream media, have already started to establish an official “bird flu” narrative. Though there is still no sign that the bird flu virus is capable of spreading […]